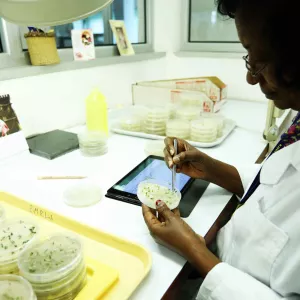

Meet CGIAR's Seed Doctors
Germplasm Health Units conduct hundreds of thousands of tests and treatments every year so that farmers, researchers and breeders can access healthy samples of crop diversity.
Germplasm Health Units conduct hundreds of thousands of tests and treatments every year so that farmers, researchers and breeders can access healthy samples of crop diversity.
The movement of pests and diseases across borders causes enormous damage to biodiversity, agriculture and food systems.
Take the fall armyworm, a pest native to the Americas, which has recently spread across Africa and Asia. It affects over 80 crops and causes billions of dollars of losses every year.

Two major banana pathogens – bunchy top virus and Fusarium Wilt Tropical Race 4 –have travelled in the opposite direction. Both originated in Asia and are now affecting farms in Africa and the Americas, raising the prospect that many of the banana varieties cultivated today will soon become unviable.

The exact cause of the international spread of these pests and diseases is unknown but it was probably linked to the movement of people, plants or plant materials in the absence of adequate quarantine controls.
As global leaders in the distribution of germplasm (seeds, tubers and other plant material), CGIAR genebanks and breeding programs have a responsibility to ensure that the material they send out is healthy and safe to use.
To address this need, CGIAR has established Germplasm Health Units (GHUs) co-located with each of its eleven genebanks around the world. They are the first line of defence against pests and diseases and, by centralising controls, provide an efficient route for compliance with safety and quarantine regulations.

In 2023 alone, GHU scientists carried out over 800,000 diagnostic tests and eliminated over 10,000 pest-contaminated samples. Their work facilitated 1,397 exports/imports between 124 countries.
The exact procedures carried out by GHUs depend on the crop, the purpose of the distribution and the regulations in the countries involved. But the labs’ work normally involves producing seeds in a low-risk environment, screening for hidden infections, and applying treatments to eliminate pests and diseases. Final products are tested using sensitive diagnostics to check their health status before they are sent out.
While they follow carefully established procedures, the GHUs cannot afford to stand still. The emergence of new risks and the need to drive efficiency means that they are constantly adding new techniques to their repertoire. That includes the use of small RNA (siRNA) sequencing to detect viruses in clonal crops and multispectral imaging to detect diseased seeds.
An independent evaluation recently noted the vital contribution that the GHUs make to CGIAR genebanks and to crop research and breeding. Over 90% of people surveyed praised the service offered by the GHUs in germplasm health testing and capacity building. The evaluators concluded that stable, reliable funding would be crucial for the GHUs to maintain their high standards in the face of growing demand and challenges.
“GHUs need continuous investment to provide a consistent service and respond to changes in the phytosanitary and policy environment.”
- CGIAR Genebank Platform: Evaluation Report, IAES, March 2024
Pests and diseases have a habit of finding the weakest link in the chain. Minimising the risk therefore needs to be a collective effort. To help raise standards, GHU scientists regularly share their expertise with national partners around the world. Germplasm requestors also need to play their part by factoring health testing into their planning – testing can take as long as two months in some cases.
Like many activities that focus on prevention, the GHU’s work often goes unnoticed. It is only newsworthy when something goes wrong.
It is impossible to quantify their impact precisely but there is every chance that GHU scientists have prevented or slowed the spread of dozens of pests and diseases around the world. Their efforts provide the foundation for the international exchange of crop diversity. And they provide excellent value for money: a recent impact case study on the GHU role in distribution of rice germplasm to Bangladesh indicated a benefit-cost ratio of 112.
Without the GHUs, it would be slower, riskier and more expensive to share materials that are vital to efforts to grow nutritious food in a changing climate.
Learn more about GHUs: https://www.mdpi.com/2223-7747/10/2/328

